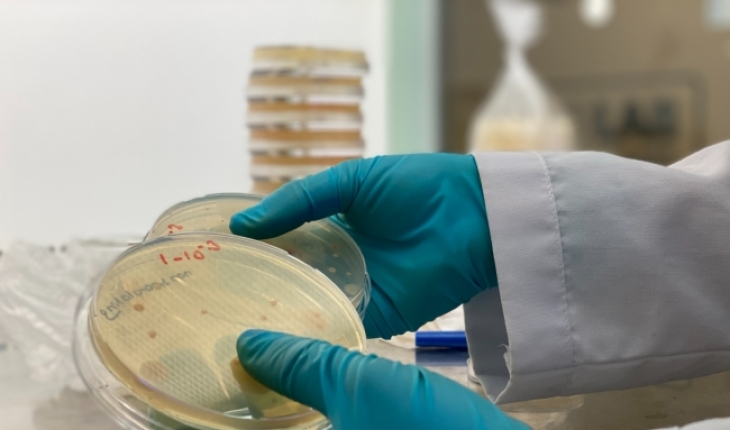

Samsun Ondokuz MayÄąs Ãniversitesi MolekÞler Biyoloji ve Genetik BÃķlÞmÞ BaÅkanÄą Prof. Dr. Nevzat Åahin ve ekibi, 60 yeni tÞr bakteri keÅfetti. Bulunan yeni tÞrlerin isimlendirilip tanÄąmlandÄąktan sonra literatÞre girmesi bekleniyor.
Reklam alanÄą
Fen-Edebiyat FakÞltesi MolekÞler Biyoloji ve Genetik BÃķlÞmÞ BaÅkanÄą Prof. Dr. Åahin ve ekibi, TÞrkiye, TÞrkmenistan, KÄąbrÄąs, Rusya, Nijerya ve Hindistan topraklarÄą ile gÃķllerinden aldÄąklarÄą Ãķrnekler Þzerinde yaptÄąklarÄą çalÄąÅmalarÄąn ardÄąndan 60 yeni tÞr bakteri keÅfetti.
2 yÄąllÄąk çalÄąÅma sonucu bulunan tÞrlerin isimlendirilip tanÄąmlandÄąktan sonra literatÞre girmesi bekleniyor.
KeÅfedilen bakteri tÞrlerinin, yeni ilaç ve antibiyotik keÅfi için de Ãķnemli adÄąm olduÄunu sÃķyleyen Prof. Dr. Åahin, TÞrkiyeânin gen kaynaklarÄąndan katma deÄer oluÅturma gayreti içinde olduklarÄąnÄą kaydetti.
Ãzerinde çalÄąÅtÄąklarÄą organizmalarÄąn daha çok aktinobakteri grubu organizmalar olduÄunu belirten Åahin, aktinobakterilerin, tedavilerde yaygÄąn olarak kullanÄąlan yÞzlerce antibiyotiÄin de elde edildiÄi mikroorganizmalar olduÄunu sÃķyledi.
Åahin, ÅÃķyle devam etti:
"KeÅfettiÄimiz organizmalarÄą, doÄal habitatlarÄą olan toprak, sediment, su, bitki, doku, kÃķk kÄąsÄąmlarÄąndan izolasyonlarÄąnÄą yapÄąyoruz. Ä°zole ettiÄimiz organizmalarÄą, uluslararasÄą standartlardaki testlere tabi tutarak tanÄąmlÄąyoruz. TanÄąmladÄąÄÄąmÄąz mikroorganizmalar içinde yeni tÞrler varsa, bunlara yine uluslararasÄą isimlendirme kurallarÄąna uygun olarak isim veriyoruz. Ãok saygÄąn dergilerde makalelerini yayÄąnlayÄąp, bu tÞrleri literatÞre kazandÄąrÄąyoruz."
"Yeni ilaç ve antibiyotik keÅiflerine yÃķnelik çalÄąÅmalarÄąmÄąz da var"
Son 2 yÄąlda da 60 yeni bakteri tÞrÞnÞ keÅfettiklerini sÃķyleyen Åahin, "Bu bakteri tÞrlerinin bÞyÞk bir çoÄunluÄu genetik Ãķzellikleri bakÄąmÄąndan antibiyotiÄin kaynaÄÄą olma ÃķzelliÄine sahiptir. Bunlarla ilgili yeni ilaç ve antibiyotik keÅiflerine yÃķnelik çalÄąÅmalarÄąmÄąz da var. Yeni ilaç keÅfine yÃķnelik çalÄąÅmamÄązÄą devlet destekledi. Son 1 yÄąldÄąr bununla ilgili Ãķnemli bulgularla ilerleyen bir çalÄąÅmamÄąz daha var. AyrÄąca bizim tanÄąmlayarak, ismini verdiÄimiz organizmalarla ilgili yeni ilaçlarÄąn keÅfine yÃķnelik çalÄąÅma yapan baÅka gruplar da var. Ãlkemizin gen kaynaklarÄąndan katma deÄer oluÅturma gayretlerimiz devam edecek" dedi.
2 yÄąllÄąk çalÄąÅma sonucu bulunan tÞrlerin isimlendirilip tanÄąmlandÄąktan sonra literatÞre girmesi bekleniyor.
KeÅfedilen bakteri tÞrlerinin, yeni ilaç ve antibiyotik keÅfi için de Ãķnemli adÄąm olduÄunu sÃķyleyen Prof. Dr. Åahin, TÞrkiyeânin gen kaynaklarÄąndan katma deÄer oluÅturma gayreti içinde olduklarÄąnÄą kaydetti.
Ãzerinde çalÄąÅtÄąklarÄą organizmalarÄąn daha çok aktinobakteri grubu organizmalar olduÄunu belirten Åahin, aktinobakterilerin, tedavilerde yaygÄąn olarak kullanÄąlan yÞzlerce antibiyotiÄin de elde edildiÄi mikroorganizmalar olduÄunu sÃķyledi.
Åahin, ÅÃķyle devam etti:
"KeÅfettiÄimiz organizmalarÄą, doÄal habitatlarÄą olan toprak, sediment, su, bitki, doku, kÃķk kÄąsÄąmlarÄąndan izolasyonlarÄąnÄą yapÄąyoruz. Ä°zole ettiÄimiz organizmalarÄą, uluslararasÄą standartlardaki testlere tabi tutarak tanÄąmlÄąyoruz. TanÄąmladÄąÄÄąmÄąz mikroorganizmalar içinde yeni tÞrler varsa, bunlara yine uluslararasÄą isimlendirme kurallarÄąna uygun olarak isim veriyoruz. Ãok saygÄąn dergilerde makalelerini yayÄąnlayÄąp, bu tÞrleri literatÞre kazandÄąrÄąyoruz."
"Yeni ilaç ve antibiyotik keÅiflerine yÃķnelik çalÄąÅmalarÄąmÄąz da var"
Son 2 yÄąlda da 60 yeni bakteri tÞrÞnÞ keÅfettiklerini sÃķyleyen Åahin, "Bu bakteri tÞrlerinin bÞyÞk bir çoÄunluÄu genetik Ãķzellikleri bakÄąmÄąndan antibiyotiÄin kaynaÄÄą olma ÃķzelliÄine sahiptir. Bunlarla ilgili yeni ilaç ve antibiyotik keÅiflerine yÃķnelik çalÄąÅmalarÄąmÄąz da var. Yeni ilaç keÅfine yÃķnelik çalÄąÅmamÄązÄą devlet destekledi. Son 1 yÄąldÄąr bununla ilgili Ãķnemli bulgularla ilerleyen bir çalÄąÅmamÄąz daha var. AyrÄąca bizim tanÄąmlayarak, ismini verdiÄimiz organizmalarla ilgili yeni ilaçlarÄąn keÅfine yÃķnelik çalÄąÅma yapan baÅka gruplar da var. Ãlkemizin gen kaynaklarÄąndan katma deÄer oluÅturma gayretlerimiz devam edecek" dedi.
Kaynak:
Reklam alanÄą
Son dakika geliÅmelerden anÄąnda haberdar olmak için WhatsApp haber kanalÄąmÄąza katÄąlÄąn.
GeliÅmelerden zamanÄąnda haberdar olmak istiyor musunuz? Google Newsâte KONHABER'e abone olun.
Yasal UyarÄą: YayÄąnlanan haberler, kÃķÅe yazÄąlarÄą, fotoÄraflar, yazÄą dizileri ve her tÞrlÞ eserin tÞm haklarÄą
Mirajans Medya Ä°letiÅim Reklam Haber ve ProdÞksiyon A.Å.'ye aittir. Kaynak gÃķsterilerek bile olsa eserin bÞtÞnÞ veya
bir kÄąsmÄą Ãķzel izin alÄąnmadan kullanÄąlamaz.
⥠BU HABERE EMOJİYLE TEPKİ VER!
ð
1
âĪïļ
0
ð
0
ðĄ
1
ð
0
ð
0
ðĒ
0
ðē
0
Toplam 2 tepki



Þlkemiz her konuda ilerliyor hayÄąrlÄą olsun
Yorum Yap
Hava yolu taÅÄąmacÄąlÄąÄÄąnda gÞmrÞk iÅlemleri dijitalleÅiyor
TÞrk Tarih Kurumunun 100 eserden oluÅan "Genel Okuyucu Dizisi KitaplarÄą" tanÄątÄąldÄą
Bosna Hersek Temsilciler Meclisi BaÅkanÄą Denis ZvizdiÄ: Kalbimiz her zaman TÞrkiyeâyle beraber
Mevlana Åehrinde "Åebiarus" yoÄunluÄu devam ediyor
TÞrkiye TaÅkÃķmÞrÞ Kurumu 263 yeni personel alacak
Konya'da tuvalette silah bulundu! Devreye polis girdi
Burhanettin Duran'dan Mevlana Celaleddin-i Rumi'nin 752. Vuslat YÄąl DÃķnÞmÞ paylaÅÄąmÄą
Konya'da jandarma ekipleri 586 adet tabanca namlusu ele geçirdi
Konya'da uyuÅturucu operasyonu! 4 kiÅi yakalandÄą
Huzurevinde eldivenli dayak! BakanlÄąk inceleme baÅlattÄą
SÄąr ÃķlÞmde miras iddiasÄą! GÞllÞ'nÞn banka hesaplarÄą inceleniyor
Bakan Yerlikaya, AFAD'Äąn kuruluÅunun 16. yÄąlÄąnÄą kutladÄą